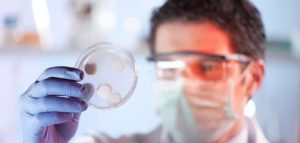

Medizinische Diagnostik: Der Wegweiser für deine Gesundheit
Die medizinische Diagnostik ist der Schlüssel zu deiner Gesundheit. Bevor eine erfolgreiche Behandlung beginnen kann, muss die genaue Ursache deiner Beschwerden gefunden werden. Von einfachen Bluttests in der Hausarztpraxis bis hin zu hochmodernen bildgebenden Verfahren wie dem MRT – die Diagnostik liefert die entscheidenden Antworten. Hier erfährst du alles über die wichtigsten Untersuchungsmethoden, wie sie ablaufen und worauf du dich bei deinem nächsten Arztbesuch vorbereiten solltest.
Differentialdiagnose von Hyperpigmentierungen: Wie Sie Altersflecken von anderen dermatologischen Befunden abgrenzen
Die korrekte Abgrenzung von Altersflecken (Lentigines seniles) von anderen Formen der Hyperpigmentierung ist für Dermatologen,...
Eigenverantwortung in der Gesundheit: Effektive Selbstchecks für ein besseres Wohlbefinden
Dieser Text beleuchtet, wie du durch eigenverantwortliche Gesundheitsfürsorge und gezielte Selbstchecks dein persönliches Wohlbefinden aktiv...
Wenn plötzliche Schwellungen auftreten: Ursachen von Angioödemen im Überblick
Plötzliche Schwellungen, insbesondere im Gesicht, an den Lippen, der Zunge, den Atemwegen oder an den...
Labortests für Zuhause zur diskreten Drogenanalyse
Wenn du nach Wegen suchst, Drogenkonsum diskret und zu Hause zu analysieren, bist du hier...
Tomographie – CT und MRT Untersuchungen
Wenn du dich fragst, welche bildgebenden Verfahren dir bei der Diagnose und Behandlung von Krankheiten...
Blutgerinnung und deren Bedeutung
Du möchtest verstehen, wie dein Körper mit Blutgerinnung lebensbedrohliche Blutverluste verhindert und welche entscheidende Rolle...
Blutuntersuchung beim Facharzt
Wenn du dich fragst, warum eine Blutuntersuchung beim Facharzt so wichtig ist und welche Erkenntnisse...
Lymphuntersuchung – wie das Lymphsystem aufgebaut ist
Du möchtest verstehen, wie dein Lymphsystem aufgebaut ist und welche Bedeutung die Lymphuntersuchung für deine...
Was ist ein Gehtest?
Du fragst dich, was genau ein Gehtest ist und warum er in der medizinischen Diagnostik...
Regelmäßige Zahnuntersuchungen sind dringend notwendig
Dieser Text erläutert die dringende Notwendigkeit regelmäßiger Zahnuntersuchungen für die Aufrechterhaltung Ihrer Mundgesundheit und Ihres...
Blutdruckmessung als Kontrolle für ein gesundes Herz
Die regelmäßige Messung deines Blutdrucks ist ein entscheidender Schritt zur proaktiven Kontrolle deiner Herzgesundheit und...
Immunologie und deren Bedeutung
Du möchtest verstehen, wie dein Körper Krankheiten abwehrt und welche zentrale Rolle das Immunsystem dabei...
Urinuntersuchung und Urinanalyse
Die Urinuntersuchung und Urinanalyse sind essenzielle diagnostische Werkzeuge, die dir helfen, eine Vielzahl von Gesundheitszuständen...
Koloskopie – DIckdarmspiegelung
Diese Informationen richten sich an dich, wenn du dich über die Dickdarmspiegelung (Koloskopie) informieren möchtest,...
Was ist eine Elektroenzephalografie (EEG)?
Die Elektroenzephalografie (EEG) ist eine nicht-invasive Methode zur Aufzeichnung der elektrischen Aktivität deines Gehirns. Sie...
Körperliche Check-up Untersuchung
Du fragst dich, warum regelmäßige körperliche Check-ups so wichtig sind und welche Untersuchungen auf dich...
Blutbilduntersuchung beim Hausarzt
Du möchtest wissen, was eine Blutbilduntersuchung beim Hausarzt genau beinhaltet, warum sie so wichtig ist...
Hämodialyse – Blutwäsche bei Nierenerkrankungen
Wenn deine Nieren nicht mehr richtig arbeiten, können sie Abfallstoffe und überschüssige Flüssigkeit nicht mehr...
Stoßwellentherapie – vielseitig anwendbar und doch umstritten
Suchst du nach einer nicht-invasiven Behandlungsmethode für hartnäckige Schmerzen und spezifische Erkrankungen des Bewegungsapparates? Dieser...
Fluoreszenz Angiografie – wie wird die Sehstörung behandelt?
Dieser Text beantwortet deine zentrale Frage: Wie wird die Sehstörung mithilfe der Fluoreszenzangiografie diagnostiziert und...
Was ist eine Echokardiographie?
Wenn du dich fragst, was eine Echokardiographie ist und warum sie eine so wichtige Rolle...
Was ist eine Harnstrahlmessung?
Du fragst dich, was eine Harnstrahlmessung genau ist und warum sie für die Diagnose von...
Einnehmbare „Bakterien auf einem Chip“
Du interessierst dich für die revolutionäre Technologie der einnehmbaren „Bakterien auf einem Chip“ und möchtest...
Hornhauttopografie – Untersuchung beim Augenarzt
Die Hornhauttopografie ist eine essenzielle Untersuchung beim Augenarzt, um die exakte Form und Beschaffenheit deiner...
Tumormarker in der Medizin
Du möchtest verstehen, was Tumormarker sind, wie sie in der medizinischen Diagnostik eingesetzt werden und...
Was sind die häufigsten Augenentzündungen?
Du möchtest wissen, welche Arten von Augenentzündungen am häufigsten auftreten und wie du sie erkennen...
Rektumuntersuchung – Untersuchung des Enddarms
Dieser Text klärt dich umfassend über die Rektumuntersuchung auf, auch bekannt als Untersuchung des Enddarms....
Die Darmspiegelung – wichtig zur Darmkrebs Vorsorge
Wenn du dich über die Darmspiegelung zur Darmkrebsvorsorge informieren möchtest, bist du hier genau richtig....
Molekulargenetik und deren Bedeutung
Dieser Text erklärt dir die Grundlagen der Molekulargenetik, ihre zentralen Konzepte und die weitreichende Bedeutung,...
Was ist ein Amsler-Gitter-Test?
Der Amsler-Gitter-Test ist ein einfacher Sehtest, der dazu dient, Veränderungen im zentralen Gesichtsfeld zu erkennen,...
Das sind die beliebtesten Diagnostik Produkte
Warum eine präzise Diagnostik lebensrettend sein kann
In der Medizin gilt ein eiserner Grundsatz: Ohne korrekte Diagnose keine zielgerichtete Therapie. Ein Symptom wie Kopfschmerzen kann harmlos sein und auf Stress oder Schlafmangel hindeuten, es kann jedoch auch das erste Anzeichen für massiven Bluthochdruck oder neurologische Ausfälle sein. Die Diagnostik dient dazu, diese Unsicherheiten auszuräumen. Sie filtert aus einer Vielzahl möglicher Krankheitsbilder exakt dasjenige heraus, das für deinen aktuellen Gesundheitszustand verantwortlich ist.
Darüber hinaus spielt die Diagnostik in der Vorsorge eine überragende Rolle. Viele ernsthafte Erkrankungen, darunter Diabetes mellitus, Bluthochdruck oder verschiedene Krebsarten, verursachen in den frühen Stadien keinerlei Schmerzen oder spürbare Einschränkungen. Erst durch routinemäßige Screening-Verfahren werden diese stillen Gefahren sichtbar gemacht. Je früher eine Krankheit durch die richtige Diagnostik erkannt wird, desto schonender und erfolgreicher kann die anschließende medizinische Intervention ausfallen.
Die Basisdiagnostik: Der erste Schritt in jeder Praxis
Nicht jede Diagnose erfordert sofort den Einsatz von Großgeräten oder hochkomplexen Laboranalysen. Die Basisdiagnostik bildet das Fundament der medizinischen Untersuchung. Sie liefert dem Arzt die ersten, oft bereits entscheidenden Hinweise auf die Natur deiner Beschwerden und entscheidet darüber, welche weiteren Schritte eingeleitet werden müssen.
Die Anamnese: Das wichtigste Gespräch für deine Gesundheit
Die Erhebung der Krankengeschichte, medizinisch Anamnese genannt, ist das mächtigste Werkzeug eines jeden Arztes. In diesem strukturierten Gespräch erfragt der Behandler nicht nur deine aktuellen Symptome, sondern beleuchtet dein gesamtes gesundheitliches Umfeld. Du wirst nach Vorerkrankungen, regelmäßiger Medikamenteneinnahme, Allergien und familiären Vorbelastungen gefragt. Auch deine Lebensgewohnheiten bezüglich Ernährung, Bewegung, Nikotin- oder Alkoholkonsum sowie dein berufliches Umfeld spielen eine wesentliche Rolle.
Eine offene und ehrliche Kommunikation deinerseits ist hierbei unerlässlich. Verschwiegene Details, aus Scham oder vermeintlicher Irrelevanz, können die Diagnosefindung erheblich verzögern oder in eine falsche Richtung lenken. Bereite dich auf dieses Gespräch vor, indem du dir im Vorfeld Notizen zu deinen Beschwerden machst: Wann treten sie auf? Wie fühlen sie sich an? Was lindert oder verschlimmert sie?
Die körperliche Untersuchung: Sehen, Hören, Fühlen
Unmittelbar nach der Anamnese folgt die körperliche Basisuntersuchung. Hier nutzt der Arzt seine Sinne sowie einfache Instrumente, um den Zustand deines Körpers zu beurteilen. Diese Untersuchung ist völlig schmerzfrei und liefert sofortige Ergebnisse.
- Inspektion: Der Arzt betrachtet deine Haut, Schleimhäute, Augen und deine Körperhaltung, um sichtbare Veränderungen wie Blässe, Schwellungen oder Asymmetrien zu erkennen.
- Auskultation: Mit dem Stethoskop werden Herz, Lunge und Darm abgehorcht. Ein unregelmäßiger Herzschlag, rasselnde Atemgeräusche oder fehlende Darmgeräusche geben direkte Hinweise auf Störungen der Organfunktionen.
- Palpation: Durch gezieltes Abtasten prüft der Arzt den Bauchraum auf Verhärtungen oder Druckschmerzen, tastet die Lymphknoten ab und beurteilt die Spannung der Muskulatur.
- Perkussion: Das Abklopfen des Körpers, insbesondere des Brustkorbs und des Bauches, erzeugt Töne, die dem Arzt verraten, ob sich Luft, Flüssigkeit oder feste Massen unter der Haut befinden.
Labordiagnostik: Was Blut, Urin und Gewebe verraten
Wenn die Basisuntersuchung nicht ausreicht oder einen bestimmten Verdacht erhärtet, ist das Labor der nächste essenzielle Schritt. Körperflüssigkeiten sind ein direkter Spiegel deiner inneren Gesundheit. Die chemische, zelluläre und mikrobiologische Analyse dieser Proben liefert harte, objektive Daten über Organfunktionen, Entzündungsprozesse und Stoffwechselvorgänge.
Das Blutbild und klinische Chemie
Die Blutabnahme gehört zu den am häufigsten durchführten diagnostischen Maßnahmen. Man unterscheidet grundsätzlich zwischen dem kleinen und dem großen Blutbild sowie den spezifischen Organwerten.
Das kleine Blutbild gibt Auskunft über die zellulären Bestandteile deines Blutes. Es misst die Anzahl der roten Blutkörperchen (Erythrozyten), die für den Sauerstofftransport zuständig sind, der weißen Blutkörperchen (Leukozyten), die deine Immunabwehr bilden, und der Blutplättchen (Thrombozyten), die für die Blutgerinnung sorgen. Zudem wird der Hämoglobinwert bestimmt. Ein Abfall dieses Wertes deutet auf eine Blutarmut (Anämie) hin.
Das große Blutbild schließt das kleine Blutbild ein und differenziert zusätzlich die verschiedenen Unterarten der weißen Blutkörperchen. Dies ist besonders wichtig, um die genaue Art einer Infektion (bakteriell oder viral) oder Erkrankungen des blutbildenden Systems zu erkennen.
Zusätzlich zum Blutbild werden Werte der klinischen Chemie bestimmt. Diese messen die Konzentration von Enzymen, Proteinen und Elektrolyten im Blutserum, um die Funktion spezifischer Organe zu überprüfen.
| Laborwert / Parameter | Was er aussagt | Hinweise zur Diagnostik |
|---|---|---|
| Leberwerte (GOT, GPT, Gamma-GT) | Zeigen Schädigungen der Leberzellen oder Störungen des Gallenabflusses an. | Können durch Alkohol, Medikamente oder Virusinfektionen (Hepatitis) erhöht sein. |
| Nierenwerte (Kreatinin, Harnstoff) | Spiegeln die Filterleistung und Entgiftungsfunktion der Nieren wider. | Kreatinin steigt oft erst an, wenn die Nierenfunktion bereits deutlich eingeschränkt ist. |
| Entzündungswerte (CRP, BSG) | Zeigen akute oder chronische Entzündungen im Körper an. | CRP reagiert sehr schnell auf bakterielle Infektionen und Gewebeschäden. |
| Schilddrüsenwerte (TSH, fT3, fT4) | Kontrollieren die Hormonproduktion der Schilddrüse. | Wichtig bei Verdacht auf Über- oder Unterfunktion der Schilddrüse. |
| Stoffwechsel (HbA1c, Cholesterin) | HbA1c ist das Blutzucker-Langzeitgedächtnis, Cholesterin zeigt das Lipidprofil. | Für die Cholesterinbestimmung musst du oft nüchtern zur Blutabnahme erscheinen. |
Urin- und Stuhldiagnostik
Eine Urinuntersuchung ist nicht nur bei Verdacht auf Blasenentzündungen relevant. Über den Urin scheidet der Körper wasserlösliche Abfallstoffe aus. Finden sich im Urin Proteine, Glukose (Zucker) oder rote Blutkörperchen, deutet dies auf Nierenerkrankungen oder einen unentdeckten Diabetes hin. Mit speziellen Teststreifen kann der Arzt diese Parameter innerhalb von Minuten direkt in der Praxis überprüfen.
Die Untersuchung einer Stuhlprobe dient in erster Linie der Früherkennung von Darmkrebs. Moderne immunologische Tests suchen nach mikroskopisch kleinen, unsichtbaren Blutspuren im Stuhl. Darüber hinaus können Stuhlproben auf Bakterien, Parasiten oder Pilze untersucht werden, wenn du unter langanhaltenden Durchfällen oder unerklärlichen Magen-Darm-Beschwerden leidest.
Bildgebende Verfahren: Ein Blick in deinen Körper
Wenn Laborwerte und körperliche Untersuchungen nicht ausreichen, um ein Organ genau zu beurteilen, kommen bildgebende Verfahren zum Einsatz. Die moderne Radiologie und Sonografie erlaubt es, das Innere deines Körpers millimetergenau darzustellen, ohne operativ eingreifen zu müssen.
Ultraschall (Sonografie): Sanft, schnell und strahlungsfrei
Die Ultraschalluntersuchung ist das am häufigsten genutzte bildgebende Verfahren. Sie arbeitet mit hochfrequenten Schallwellen, die für das menschliche Ohr nicht hörbar sind. Ein Schallkopf sendet diese Wellen in den Körper, wo sie von den verschiedenen Geweben und Organen unterschiedlich stark reflektiert werden. Der Computer berechnet aus diesen Echos in Echtzeit ein Schwarz-Weiß-Bild auf dem Monitor.
Da Ultraschall völlig frei von schädlicher Strahlung ist, ist er die Methode der Wahl in der Schwangerschaftsvorsorge sowie bei der Untersuchung von Kindern. Auch die Bauchorgane (Leber, Gallenblase, Nieren), die Schilddrüse und das Herz können mit der Sonografie hervorragend beurteilt werden. Ein Nachteil der Methode ist lediglich, dass Schallwellen Knochen und Luft schlecht durchdringen, weshalb sie für die Untersuchung des Gehirns oder der Lunge weniger geeignet ist.
Röntgen: Der Standard für Knochen und Lunge
Das Röntgen nutzt elektromagnetische Strahlen, die den Körper durchdringen und auf einem Detektor ein Bild erzeugen. Dichtes Gewebe, wie deine Knochen, absorbiert viel Strahlung und erscheint auf dem Bild weiß. Weichteile und luftgefüllte Räume, wie die Lunge, lassen die Strahlung passieren und werden dunkel dargestellt.
Röntgen ist unerlässlich in der Unfallchirurgie, um Knochenbrüche oder Gelenkverschleiß (Arthrose) darzustellen. Auch in der Zahnmedizin und bei der Diagnostik von Lungenentzündungen ist es Standard. Obwohl die Strahlenbelastung bei modernen digitalen Röntgengeräten extrem gering ist, wird die Untersuchung nur durchgeführt, wenn ein strenger medizinischer Nutzen vorliegt.
Computertomografie (CT): Der detaillierte Querschnitt
Die Computertomografie basiert ebenfalls auf Röntgenstrahlen. Im Gegensatz zum normalen Röntgenbild, das eine zweidimensionale Projektion liefert, rotiert bei der CT eine Röntgenröhre ringförmig um deinen Körper. Der Computer setzt aus unzähligen Einzelaufnahmen extrem detaillierte, überlagerungsfreie Schnittbilder zusammen.
Eine CT-Untersuchung dauert nur wenige Minuten und eignet sich hervorragend für die Notfalldiagnostik, beispielsweise nach schweren Unfällen, um innere Blutungen aufzuspüren, oder bei Verdacht auf einen Schlaganfall. Auch feinste Knochenstrukturen und Lungengewebe werden gestochen scharf abgebildet. Aufgrund der höheren Strahlenbelastung im Vergleich zum normalen Röntgen wird die CT jedoch mit Bedacht eingesetzt.
Magnetresonanztomografie (MRT): Höchste Präzision für Weichteile
Die Magnetresonanztomografie, auch Kernspintomografie genannt, arbeitet völlig ohne Röntgenstrahlung. Sie nutzt ein extrem starkes Magnetfeld und Radiowellen, um die Wasserstoffatome in deinem Körper auszurichten und Signale zu erzeugen. Daraus berechnet der Computer Bilder von unübertroffener Qualität, insbesondere wenn es um weiches Gewebe geht.
Das MRT ist die absolut beste Methode, um das Gehirn, das Rückenmark, Bänder, Sehnen, Knorpel und innere Organe darzustellen. Es kann Tumore, Entzündungsherde bei Multipler Sklerose oder Bandscheibenvorfälle millimetergenau lokalisieren. Die Untersuchung dauert zwischen 15 und 45 Minuten, während der du sehr still in einer Röhre liegen musst. Da das Gerät laute Klopfgeräusche erzeugt, erhältst du Gehörschutz. Für Patienten mit Herzschrittmachern oder bestimmten Metallimplantaten ist das MRT aufgrund des extremen Magnetfeldes oft nicht geeignet.
Funktionsdiagnostik: Wie gut arbeiten deine Organe?
Während bildgebende Verfahren zeigen, wie deine Organe aussehen, zeigt die Funktionsdiagnostik, wie gut sie arbeiten. Diese Tests messen elektrische Ströme, Druckverhältnisse oder Volumenströme unter Ruhebedingungen oder unter gezielter Belastung.
Herzdiagnostik: Das EKG
Das Elektrokardiogramm (EKG) misst die elektrischen Impulse, die den Herzschlag steuern. Über Saugelektroden, die auf Brustkorb, Armen und Beinen angebracht werden, leitet das Gerät die Ströme ab und zeichnet sie als Kurven auf. Das Ruhe-EKG zeigt akute Rhythmusstörungen oder einen frischen Herzinfarkt. Beim Belastungs-EKG, das meist auf einem feststehenden Fahrrad (Ergometer) durchgeführt wird, wird geprüft, ob dein Herz unter körperlicher Anstrengung ausreichend mit Sauerstoff versorgt wird. Das Langzeit-EKG überwacht deinen Herzrhythmus über 24 Stunden, um seltene, nur sporadisch auftretende Rhythmusstörungen zu erfassen.
Lungendiagnostik: Die Spirometrie
Um festzustellen, ob du an Asthma, COPD (chronisch obstruktiver Lungenerkrankung) oder anderen Atemwegserkrankungen leidest, wird ein Lungenfunktionstest durchgeführt. Bei der Spirometrie atmest du über ein spezielles Mundstück in ein Messgerät. Der Arzt fordert dich auf, maximal einzuatmen und anschließend so schnell und kräftig wie möglich auszuatmen. Das Gerät misst dabei dein Lungenvolumen und den Luftstrom. Verengte Atemwege lassen sich durch diese schnelle, schmerzfreie Methode sofort erkennen.
Neurologische Funktionsmessung: EEG und EMG
Das Elektroenzephalogramm (EEG) misst die elektrischen Gehirnströme über Elektroden auf der Kopfhaut. Es ist essenziell für die Diagnose von Epilepsie oder Schlafstörungen. Die Elektromyografie (EMG) und die Elektroneurografie (ENG) prüfen die Funktion deiner Muskeln und Nerven. Hierbei wird gemessen, wie schnell ein Nerv elektrische Reize weiterleitet, was bei Verdacht auf Nervenverletzungen oder Erkrankungen wie dem Karpaltunnelsyndrom wichtig ist.
Endoskopie: Der sichere Blick von innen
Die Endoskopie erlaubt es dem Arzt, natürliche Körperhöhlen und Hohlorgane von innen zu betrachten. Hierfür wird ein Endoskop – ein flexibler Schlauch mit einer winzigen Kamera und einer Lichtquelle an der Spitze – in den Körper eingeführt. Der entscheidende Vorteil der Endoskopie gegenüber bildgebenden Verfahren ist, dass der Arzt während der Untersuchung über kleine Arbeitskanäle im Schlauch sofort Gewebeproben (Biopsien) entnehmen oder kleine Eingriffe durchführen kann.
Die Magenspiegelung (Gastroskopie)
Bei der Magenspiegelung führt der Arzt das Endoskop über den Mund durch die Speiseröhre bis in den Magen und den Zwölffingerdarm. Diese Untersuchung wird durchgeführt bei anhaltendem Sodbrennen, unerklärlichen Magenschmerzen, Schluckbeschwerden oder Verdacht auf Magengeschwüre. Um die Untersuchung für dich so angenehm wie möglich zu machen, wird der Rachen örtlich betäubt. Auf Wunsch erhältst du eine kurze Schlafspritze, sodass du von dem Eingriff absolut nichts mitbekommst.
Die Darmspiegelung (Koloskopie)
Die Darmspiegelung ist die Goldstandard-Untersuchung zur Früherkennung von Darmkrebs und wird ab dem 50. Lebensjahr als Vorsorgeleistung empfohlen. Das Endoskop wird über den After eingeführt und der gesamte Dickdarm betrachtet. Entdeckt der Arzt dabei Vorstufen von Krebs, sogenannte Polypen, kann er diese noch in derselben Sitzung schmerzfrei mit einer kleinen Elektroschlinge entfernen. Um eine klare Sicht zu gewährleisten, muss der Darm im Vorfeld durch spezielle Trinklösungen vollständig entleert und gereinigt werden. Auch diese Untersuchung wird heute standardmäßig im Dämmerschlaf durchgeführt.
Genetik und molekulare Diagnostik: Die Medizin der Zukunft
Die fortschreitende Entwicklung in der Medizin erlaubt es mittlerweile, Erkrankungen bis auf die Ebene unserer DNA zurückzuverfolgen. Die genetische Diagnostik analysiert das Erbgut aus einer Blut- oder Speichelprobe, um angeborene Genmutationen zu finden. Dies hat das Potenzial, die Medizin der kommenden Jahrzehnte massiv zu verändern.
Besonders in der Onkologie rettet die molekulare Diagnostik Leben. Wenn in einer Familie gehäuft Brust- oder Eierstockkrebs auftritt, kann ein Test auf Mutationen in den BRCA-Genen Gewissheit bringen. Trägt eine Frau diese Mutation, kann durch engmaschige Vorsorgeprogramme oder prophylaktische Operationen der Ausbruch der Krankheit oft verhindert werden.
Auch bei der medikamentösen Behandlung spielt die Genetik eine zunehmende Rolle. Die sogenannte Pharmakogenetik untersucht, wie deine individuellen Gene den Abbau von Medikamenten beeinflussen. So kann der Arzt im Vorfeld testen, ob ein bestimmtes Krebsmedikament oder Antidepressivum bei dir wirken wird, oder ob schwere Nebenwirkungen zu erwarten sind. Dies ist der Wegbereiter für eine stark personalisierte, maßgeschneiderte Medizin.
Vorbereitung auf diagnostische Eingriffe: Deine aktive Rolle
Die Qualität vieler Untersuchungsergebnisse hängt direkt davon ab, wie gut du dich darauf vorbereitest. Das medizinische Personal wird dir vor jedem Eingriff genaue Anweisungen geben. Deine Aufgabe ist es, diese strikt zu befolgen.
- Nüchternheit beachten: Wenn du zur Blutabnahme (insbesondere für Blutzucker oder Cholesterin) oder zu einer Ultraschalluntersuchung des Bauches gebeten wirst, nüchtern zu erscheinen, bedeutet dies: Acht bis zwölf Stunden vorher nichts mehr essen, keine zuckerhaltigen Getränke, kein Kaffee mit Milch und kein Kaugummi. Reines Wasser ist meist erlaubt.
- Medikamente absprechen: Einige Medikamente verfälschen Laborwerte oder erhöhen das Blutungsrisiko bei endoskopischen Eingriffen. Kläre immer rechtzeitig mit deinem Arzt ab, ob du blutverdünnende Mittel, Diabetesmedikamente oder Schilddrüsenhormone am Morgen der Untersuchung wie gewohnt einnehmen darfst.
- Metall ablegen: Wenn du einen Termin für ein MRT hast, musst du sämtliche metallischen Gegenstände entfernen. Dazu gehören Schmuck, Uhren, Piercings, Haarnadeln und Kleidung mit Reißverschlüssen oder Metallknöpfen. Informiere das Personal zwingend über Implantate, Tattoos (einige Farben enthalten Metallpartikel) oder Granatsplitter im Körper.
- Allergien kommunizieren: Vor CT- oder MRT-Untersuchungen wird dir oft ein Kontrastmittel über die Vene gespritzt, um Gewebe besser abzugrenzen. Wenn du eine bekannte Allergie gegen jodhaltige Kontrastmittel, eine Schilddrüsenüberfunktion oder eine Nierenschwäche hast, muss der Arzt dies im Vorfeld wissen, um Schutzmaßnahmen zu ergreifen oder auf eine andere Methode auszuweichen.
FAQ: Häufig gestellte Fragen zur Diagnostik
Ist die Strahlenbelastung beim Röntgen gefährlich für mich?
Die Dosis bei einem normalen Röntgenbild, etwa der Lunge oder eines Knochens, ist heutzutage extrem gering und entspricht in etwa der natürlichen Umgebungsstrahlung, der du während eines Transatlantikfluges ausgesetzt bist. Die Gefahr durch eine übersehene Fraktur oder Lungenentzündung ist weitaus größer als das Risiko der einmaligen Strahlung. Dennoch gilt das Prinzip der Rechtfertigung: Es wird nur geröntgt, wenn es medizinisch notwendig ist.
Ich habe extreme Platzangst. Wie überstehe ich ein MRT?
Platzangst (Klaustrophobie) ist ein häufiges Problem beim MRT. Sprich das radiologische Personal offen darauf an. Viele Praxen bieten an, dir vor der Untersuchung ein leichtes Beruhigungsmittel zu verabreichen (dann darfst du danach aber nicht selbst Auto fahren). Zudem gibt es mittlerweile sogenannte „offene MRT-Geräte“ oder Geräte mit einer extra weiten Röhrenöffnung, die viel mehr Freiraum bieten und die Untersuchung deutlich angenehmer machen.
Warum muss ich für manche Bluttests unbedingt nüchtern sein?
Nahrung und Getränke (insbesondere solche mit Zucker, Fett oder Koffein) verändern kurzfristig die Zusammensetzung deines Blutes. Dein Blutzuckerspiegel und die Blutfettwerte (Triglyceride) steigen nach dem Essen rasant an. Auch bestimmte Hormone und Leberenzyme reagieren auf Nahrungsaufnahme. Um verlässliche, vergleichbare Basiswerte zu erhalten, muss die Blutentnahme daher auf leeren Magen erfolgen.
Tut eine Gewebeentnahme (Biopsie) während einer Spiegelung weh?
Nein, du spürst davon in der Regel absolut nichts. Die Darmschleimhaut und die Magenschleimhaut besitzen keine Schmerzrezeptoren, die auf das kleine Zupfen der Biopsiezange reagieren. Selbst wenn du die Spiegelung ohne Dämmerschlaf wach miterlebst, ist die Entnahme der millimeterkleinen Proben völlig schmerzlos.
Kann der Arzt alle Krankheiten nur durch das Blutbild feststellen?
Das Blutbild ist extrem aufschlussreich, aber es ist kein allwissendes Orakel. Es gibt viele Erkrankungen, die keine spezifischen Spuren im Blut hinterlassen. Beispielsweise lassen sich Arthrose, ein Bandscheibenvorfall, viele Nervenerkrankungen oder frühe Stadien lokaler Tumore nicht allein durch eine Blutuntersuchung diagnostizieren. Das Blutbild ist immer nur ein Puzzleteil im gesamten diagnostischen Prozess.
Wie lange dauert es, bis ich meine Befunde aus dem Labor bekomme?
Das hängt von der Art der Untersuchung ab. Standard-Blutwerte und einfache Urinuntersuchungen wertet das Labor oft innerhalb von 24 Stunden aus. Wenn spezielle Hormonanalysen, immunologische Tests oder mikrobiologische Kulturen (Züchtung von Bakterien zur Antibiotika-Testung) angefordert werden, kann es mehrere Tage bis zu einer Woche dauern, bis alle Ergebnisse vollständig beim Arzt vorliegen.